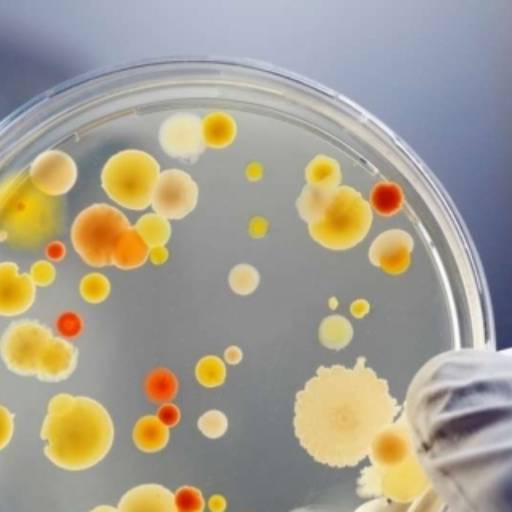
MICROBIOLOGIA por Bioclínica Análises Clínicas

Este campo de aplicação está relacionado ao controle e prevenção de doenças e associado às práticas assépticas, antibioticoterapia, quimioterapia e imunização, bem como com a epidemiologia ou epizootiologia e os métodos de diagnóstico das doenças infecciosas.
O setor de microbiologia dentro do laboratório de análises clínicas desempenha um papel fundamental. Dentre suas principais atribuições pode-se destacar:
– Isolamento e identificação de microrganismo envolvido em um processo infeccioso. – Determinação do perfil de sensibilidade aos antimicrobianos para uso racional dos antibióticos.
– Vigilância de microrganismos resistentes a vários ou até mesmo a todos os antibióticos.
– Fornecimento de dados epidemiológicos dos diferentes agentes etiológicos de infecção hospitalar e perfil de sensibilidade.
– Suporte microbiológico na investigação de surto